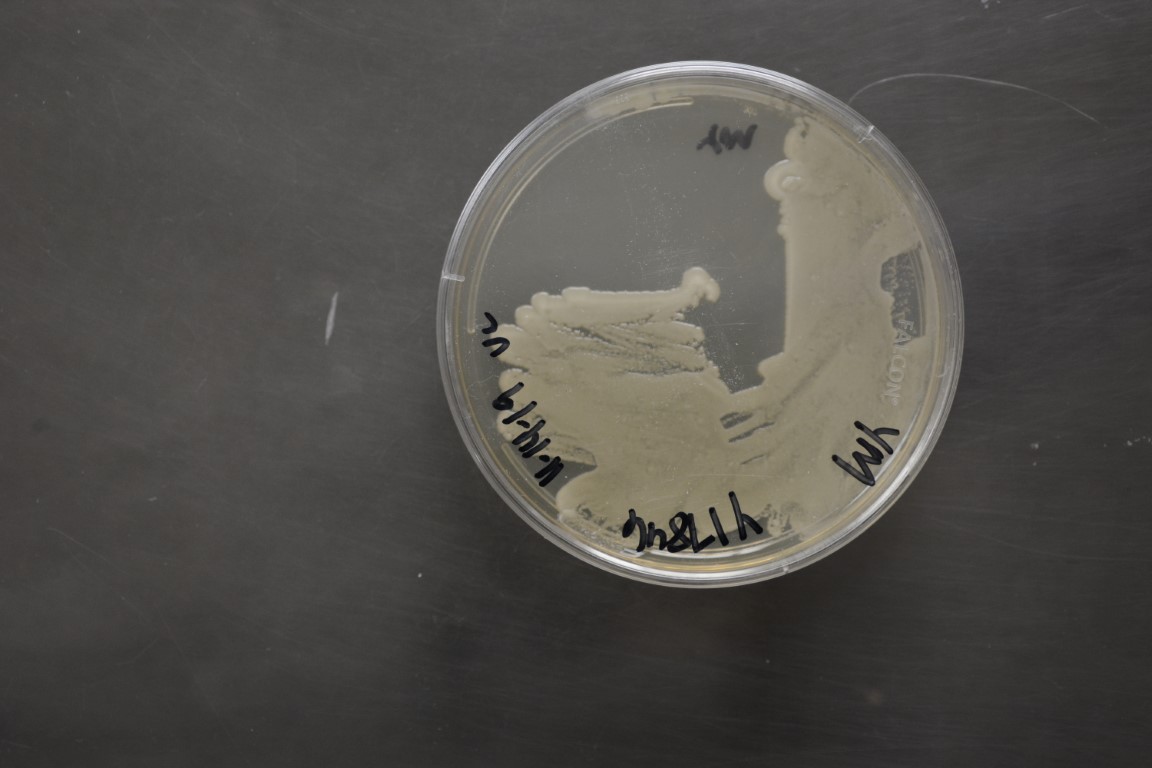

Nakaseomyces bacillisporus
NRRL Y-17846(Type Strain)
Accession numbers in other collections:CBS 7720
Source:D.Yarrow,CBS,Delft,The Netherlands
Isolated from(substrate):FX,Emory oak(Quercus emoryi)exudate
Substrate location:Arizona,USA
Genetic info:Robnett PCR#685.GenBank:LSU(AY046118),SSU(AY046252),ITS(AY046195),EF-1 alpha(AF402065),mito SSU(AF442328),D1/D2(U69583).
Growth media:Yeast Extract-Malt Extract-Peptone-Glucose(YM for yeasts)(number 6)
Optimum growth temperature:25C
Strain images:
NRRL_Y-17846_6.JPG